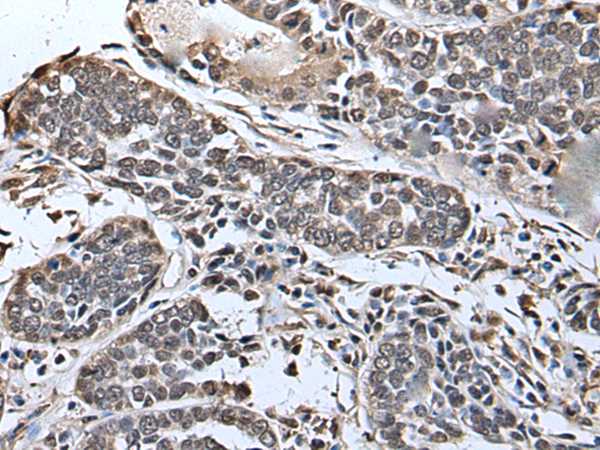

-
分类: 科研抗体货号: P08802别名: HH17应用: WB,IHC反应种属: Human, Mouse
-
分类: 科研抗体货号: P08780别名: DFNMYP应用: IHC反应种属: Human, Mouse
-
分类: 科研抗体货号: P08801别名: IGAN3; hSPRY2应用: WB,IHC反应种属: Human, Mouse
-
分类: 科研抗体货号: P08779别名: LRRC11; bA364G4.2应用: IHC反应种属: Human, Mouse
-
分类: 科研抗体货号: P08777别名: NET34; ZIP14; cig19; LZT-Hs4应用: IHC反应种属: Human, Mouse
-
分类: 科研抗体货号: P08799别名: SLIC1应用: IHC反应种属: Human
-
分类: 科研抗体货号: P08808别名:应用: IHC反应种属: Human
-
分类: 科研抗体货号: P08797别名:应用: WB反应种属: Human, Mouse
-
分类: 科研抗体货号: P08807别名: SSA2; RORNP; TROVE2应用: WB反应种属: Human, Mouse
-
分类: 科研抗体货号: P08796别名:应用: WB,IHC反应种属: Human, Mouse

鄂公网安备42018502007531号
鄂公网安备42018502007531号

